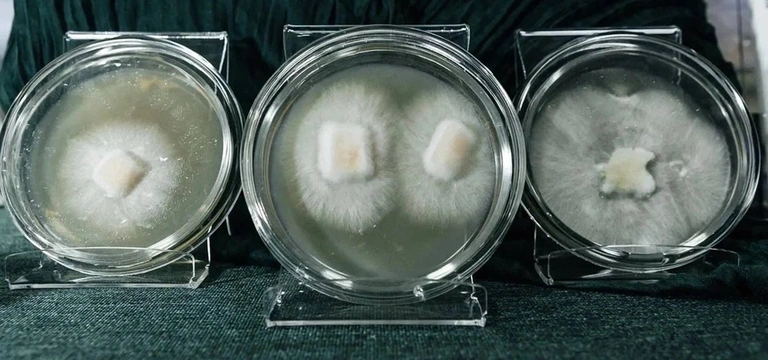
Я выращиваю мебель из&nbsp;грибов и&nbsp;мусора. Посмотрите сами

Дарья Токарева «скармливает» неперерабатываемые отходы грибам и делает из них дизайнерскую мебель. Рассказываем, как 26-летняя девушка из Кургана запустила производство, аналогов которому нет.


На стыке промышленного дизайна и экоактивизма
Что общего у использованного стаканчика кофе, грязной коробки из-под пиццы, чека и окурка? Они непригодны для стандартной переработки. Дарья придумала, как из всего этого выращивать новый материал — аналог древесины. Именно выращивать, ведь в основе отечественной технологии — гриб. Мицелий поглощает отходы, разлагает примеси и формирует новое изделие всего за пять дней.

«Я училась на промышленного дизайнера в Академии Штиглица. Там вместе со знаниями культивировали философию создания долговечных, красивых и удобных вещей — для людей. Тогда же вне занятий я участвовала в студенческих экологических инициативах: мы сортировали мусор, организовывали субботники, занимались экопросвещением.
Параллельно работала по специальности и видела изнутри, как действует проектирование вещей для массового сегмента и сколько неперерабатываемых отходов образуется на предприятии ежедневно».
Идея Дарьи — создать уникальное производство на грани рентабельного бизнеса и экологичных принципов. А сделать это можно используя биотехнологии.
«Грибы уникальны: то, как они растут, как могут переработать под землёй червяка. Но чтобы использовать их в промышленном дизайне, нужны научные компетенции — а у меня их нет. Так, спустя кучу времени поисков в отчаянии, я нашла биотехнолога, миколога Артёма Баркова. Порядка 40 лет он коллекционировал штаммы мицелия и тестировал их. Сегодня он вместе со мной основатель компании SPAWN».
Слово spawn переводится с английского как «порождать», «размножаться», «мицелий», «грибница». В компании в это слово закладывают больше: для них спаун — это перерождение, вторая жизнь, возможность неперерабатываемых отходов реинкарнироваться в прекрасные предметы интерьера.
«Всё начиналось не как стартап, а как домашняя инициатива. Первые эксперименты я проводила на подоконнике коммуналки, а Артём — у себя после работы. Сначала мы хотели перерабатывать отходы в компост, но, посчитав рентабельность, поняли, что такой бизнес будет убыточен.
Потом обратили внимание, что при определённых условиях грибы не только ферментируют отходы, но и выстраиваются в жёсткую структуру. Так случайно мы создали, по сути, новую древесину, а из неё — дизайнерскую мебель и предметы интерьера».
«Настольная» инициатива, возникшая четыре года назад у Дарьи Токаревой, переросла в формат сначала первой открытой лаборатории, затем опытного производства, первых заказов, а теперь — предприятия площадью 400 кв. м, запущенного в ноябре 2024 года.
Как заставить гриб есть мусор
На производстве SPAWN введён режим повышенной секретности, ведь здесь применяется уникальная разработка, аналогов которой не существует.
«У нас производство ноу-хау, и мы редко показываем технологическую линию, чтобы уберечь разработку от плагиата. Мы не только первые в мире вывели и запатентовали особенные штаммы грибов, но и смогли создать технологический цикл, не существовавший до этого в принципе. К слову, конвейер на линиях мы продолжаем оттачивать и сегодня: он полностью состоит из идей и разработок наших “Кулибиных”». Если общими словами описывать процесс создания новых вещей, то он состоит из нескольких этапов.
- Прежде чем скормить грибам мусор, отходы без разделения на пластик и целлюлозу измельчают и подвергают термической обработке посредством автоклава. Это нужно, чтобы в сырье не осталось посторонних бактерий и грибов.
- После «прожарки» измельчённый мусор засевают грибами, выращенными в лаборатории, и выкладывают в специальные формы, как гипс или тесто.
Технология позволяет выращивать готовое изделие. Например, полки, столешницы, вазы. Если нужно, то сразу с дизайнерским узором. Для этого на дно формы выкладывают фигурки из оргстекла, которые гриб потом обрастает. Через пять дней процесс питания грибов останавливают, а полученная масса белеет и затвердевает. На выходе мы получаем кусок органики, который можно использовать как есть или обработать: резать, шлифовать, окрашивать.
По характеристикам полученный материал — аналог древесины, но его себестоимость в разы ниже. Наше новое производство в Петербурге за месяц может переработать 8 тонн отходов и создать 10 тонн уникальных изделий.
Нас часто спрашивают про безвредность продукта. Конечно, мы проводили все соответствующие исследования на безопасность как производства, так и материала. Он по своим свойствам — почти то же самое, что и срубленная сосна, при этом он хуже горит и может быть переработан в нашем производственном цикле».
Куда растёт гриб
«Сейчас мы применяем штаммы грибов, которые называем рабочими лошадками: это наша интеллектуальная собственность. С их помощью выращиваем новый материал — аналог ДСП, из которого создаём дизайнерскую мебель и предметы интерьера.
При помощи других штаммов мы производим сырье для биоразлагаемой упаковки и сейчас разрабатываем новый тепло- и шумоизоляционный материал.
Мы продолжаем изучать новые типы материалов и отходов, чтобы использовать не только пластик с бумагой. Сейчас, например, совместно с международным партнёром пилотируем направление по переработке неликвидной косметики: самого продукта, а не упаковки. Плюсом сюда идут текстильные маски для лица. До сегодняшнего дня их никто не брался перерабатывать.
С другим партнёром пилотируем направление по биоразлагаемым урнам для праха домашних питомцев, которые можно захоранивать в земле. В крышки таких урн будут подсаживаться семена растений, которые со временем взойдут и превратятся в цветы или деревья, а покинувшие нас питомцы оставят за собой зелёный след.
Направлений множество, мы постоянно находимся в поиске и исследуем новое».
А вы бы купили мебель из грибов? Как относитесь к таким инициативам? Пишите в комментариях.